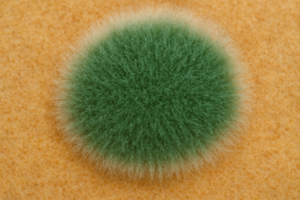
Macroscopic morphology of G. virens

Dalam dunia pertanian berkelanjutan, peran mikroorganisme semakin mendapat sorotan karena terbukti mampu membantu petani mengurangi ketergantungan pada pestisida dan pupuk kimia. Salah satu jamur yang cukup menonjol adalah Gliocladium virens, yang kini lebih dikenal dengan nama Trichoderma virens setelah diklasifikasikan ulang secara taksonomi (Kredics et al., 2001). Meski namanya tidak sepopuler Trichoderma harzianum atau Trichoderma asperellum, jamur ini menyimpan potensi besar sebagai agen hayati, baik untuk melawan patogen tanah maupun meningkatkan kesehatan tanaman.
Gliocladium virens memiliki peran penting dalam ekosistem rhizosfer, terutama sebagai agen hayati yang bersinergi dengan spesies Trichoderma lainnya. Sebagai partner biologis, G. virens berkontribusi dalam mengendalikan berbagai patogen tular tanah melalui mekanisme kompetisi ruang dan nutrisi, produksi metabolit antijamur seperti gliotoksin, serta aktivitas mikoparasitisme. Sinerginya dengan Trichoderma harzianum maupun Trichoderma asperellum memperkuat efektivitas pengendalian hayati, karena masing-masing spesies memiliki mekanisme spesifik yang saling melengkapi, baik melalui produksi enzim hidrolitik, senyawa antibiotik, maupun kemampuan kolonisasi akar tanaman.

Gliocladium virens merupakan jamur tanah yang secara alami hidup di daerah perakaran (rhizosfer). Lingkungan ini sangat kaya interaksi biologis, sehingga jamur ini berkembang dengan baik di sana. Ia dikenal mampu menghasilkan berbagai metabolit sekunder yang bersifat antibiotik, salah satunya adalah gliotoxin, senyawa dengan kemampuan menekan pertumbuhan jamur patogen (Wilhite & Straney, 1996). Berbeda dari pestisida kimia yang bekerja secara instan namun meninggalkan residu, aktivitas antibiotik dari G. virens berlangsung secara alami sehingga tidak mencemari lingkungan dan relatif aman bagi organisme non-target.
Peran utamanya sebagai agen pengendali hayati (biological control agent) sudah banyak dibuktikan. Penelitian awal oleh Howell (1982) menunjukkan bahwa G. virens efektif melawan Rhizoctonia solani, patogen penyebab penyakit rebah semai yang sering menyerang tanaman hortikultura. Tidak hanya itu, jamur ini juga terbukti menekan perkembangan Sclerotium rolfsii dan Pythium spp., dua patogen yang menjadi penyebab utama busuk pangkal batang dan busuk akar pada berbagai tanaman (Lumsden & Locke, 1989). Mekanisme pengendalian yang dilakukan meliputi kompetisi memperebutkan ruang dan nutrisi, produksi antibiotik, hingga mikoparasitisme, yaitu menyerang langsung hifa patogen (Howell, 2003).
Keunikan lain dari Gliocladium virens adalah kemampuannya menghasilkan senyawa volatil yang bersifat antibakteri dan antijamur. Penelitian oleh Lewis & Papavizas (1984) menemukan bahwa senyawa volatil tersebut dapat menekan pertumbuhan patogen secara signifikan di lingkungan tanah. Artinya, jamur ini tidak hanya berinteraksi secara fisik dengan patogen, tetapi juga memanfaatkan senyawa kimia yang dilepaskan ke sekitarnya untuk menciptakan kondisi tidak ramah bagi organisme penyebab penyakit. Hal ini menambah keunggulan kompetitifnya dibandingkan agen hayati lain.

Tidak hanya melawan patogen, G. virens juga berperan dalam mendukung pertumbuhan tanaman secara tidak langsung. Sejumlah penelitian melaporkan bahwa tanaman yang diinokulasi dengan jamur ini cenderung memiliki sistem perakaran yang lebih sehat dan lebih banyak cabang akar (Harman et al., 2004). Kondisi ini tentu meningkatkan kemampuan tanaman dalam menyerap air dan nutrisi. Selain itu, adanya perlindungan dari penyakit membuat energi tanaman dapat lebih difokuskan untuk pertumbuhan vegetatif maupun generatif. Dampak akhirnya adalah peningkatan hasil panen dan kualitas produk.
Di lapangan, G. virens telah diuji pada berbagai komoditas. Misalnya, penelitian oleh Howell & Stipanovic (1995) membuktikan bahwa inokulasi G. virens pada kapas mampu menekan penyakit busuk akar akibat Rhizoctonia dan pada saat yang sama meningkatkan hasil kapas. Studi lain oleh Chet et al. (1997) menunjukkan efektivitasnya pada tanaman sayuran, khususnya dalam mengurangi insiden penyakit tular tanah. Fakta ini menjadikannya kandidat kuat untuk aplikasi komersial dalam bentuk biofungisida maupun pupuk hayati.
Keunggulan dari penggunaan G. virens jelas terlihat dalam aspek keberlanjutan. Dengan mengurangi kebutuhan fungisida sintetis, residu kimia yang merusak tanah dan air dapat ditekan. Jamur ini juga tidak menimbulkan resistensi secepat bahan kimia, sebab mekanisme pengendaliannya bersifat majemuk dan melibatkan interaksi biologis kompleks (Vinale et al., 2008). Hal ini membuatnya lebih aman untuk digunakan dalam jangka panjang, sekaligus mendukung tren pertanian organik yang semakin diminati.
Namun, sama seperti agen hayati lain, Gliocladium virens juga memiliki keterbatasan. Efektivitasnya sangat dipengaruhi oleh kondisi lingkungan, seperti kelembapan tanah, suhu, dan ketersediaan bahan organik (Harman et al., 2004). Jika kondisi terlalu ekstrem atau tidak sesuai, kinerjanya bisa menurun. Oleh karena itu, aplikasi di lapangan perlu memperhatikan faktor pendukung agar populasinya bisa bertahan dan berfungsi optimal. Konsistensi penggunaan serta integrasi dengan praktik budidaya lain menjadi kunci keberhasilan.
Secara keseluruhan, Gliocladium virens adalah contoh nyata bagaimana mikroorganisme kecil mampu memberi dampak besar dalam sistem pertanian. Dari hasil-hasil penelitian hingga penerapan di lapangan, jamur ini terbukti memiliki kemampuan ganda: melawan patogen berbahaya sekaligus meningkatkan kesehatan tanaman. Dengan semakin banyaknya bukti ilmiah yang mendukung, besar kemungkinan G. virens akan semakin dilirik sebagai bagian penting dari strategi pengendalian hayati. Pertanian masa depan tampaknya akan lebih mengandalkan agen hayati semacam ini, demi terciptanya sistem produksi pangan yang sehat, ramah lingkungan, dan berkelanjutan.
Referensi
- Chet, I., Inbar, J., & Hadar, I. (1997). Fungal antagonists and mycoparasites. In G. C. Carroll & P. Tudzynski (Eds.), The Mycota IV: Environmental and Microbial Relationships (pp. 165–184). Springer.
- Harman, G. E., Howell, C. R., Viterbo, A., Chet, I., & Lorito, M. (2004). Trichoderma species—opportunistic, avirulent plant symbionts. Nature Reviews Microbiology, 2(1), 43–56. https://doi.org/10.1038/nrmicro797
- Howell, C. R. (1982). Effect of Gliocladium virens on Pythium ultimum, Rhizoctonia solani, and damping-off of cotton seedlings. Phytopathology, 72(4), 496–498. https://doi.org/10.1094/Phyto-72-496
- Howell, C. R., & Stipanovic, R. D. (1995). Mechanisms in the biocontrol of Rhizoctonia solani-induced cotton seedling disease by Gliocladium virens: Antibiosis. Phytopathology, 85(5), 469–472. https://doi.org/10.1094/Phyto-85-469
- Kredics, L., Antal, Z., Manczinger, L., Szekeres, A., Kevei, F., & Nagy, E. (2001). Influence of environmental parameters on Trichoderma strains with biocontrol potential. Food Technology and Biotechnology, 39(1), 37–42.
- Lewis, J. A., & Papavizas, G. C. (1984). Characteristics of Gliocladium virens antagonistic to Rhizoctonia solani and Pythium spp. Phytopathology, 74(7), 833–840. https://doi.org/10.1094/Phyto-74-833
- Lumsden, R. D., & Locke, J. C. (1989). Biological control of damping-off caused by Pythium ultimum and Rhizoctonia solani with Gliocladium virens in soilless mix. Phytopathology, 79(3), 361–366. https://doi.org/10.1094/Phyto-79-361
- Vinale, F., Sivasithamparam, K., Ghisalberti, E. L., Woo, S. L., & Lorito, M. (2008). Trichoderma–plant–pathogen interactions. Soil Biology and Biochemistry, 40(1), 1–10. https://doi.org/10.1016/j.soilbio.2007.07.002
- Wilhite, S. E., & Straney, D. C. (1996). Timing of gliotoxin biosynthesis in Gliocladium virens and its role in biological control of Pythium ultimum. Applied and Environmental Microbiology, 62(12), 3929–3934. https://doi.org/10.1128/aem.62.12.3929-3934.1996

